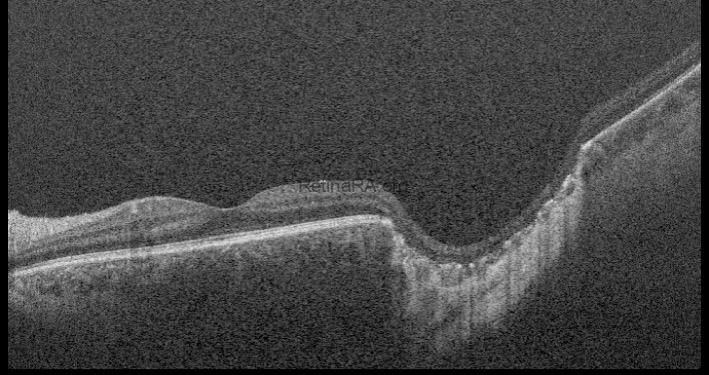
db304d96-9b7e-4f5a-9a80-a3deac9a005fNNPDTAB

A 30-year-old man presents to the clinic with a complaint of foreign body sensation and redness in his left eye. He has no significant medical history. Visual acuity is 10/10 in both eyes with astigmatic correction (with-the-rule).
Anterior segment examination reveals mild, nonspecific conjunctival hyperemia in both eyes. The corneas are clear and specular; the lenses are in place and transparent. Intraocular pressure is 12 mmHg in the right eye (RE) and 13 mmHg in the left eye (LE). After instillation of a mydriatic agent (Tropicamide 1%), fundus examination is unremarkable in the RE. In the LE, a pigmented, atrophic lesion is observed in the retina, temporal to the fovea. The vitreous is clear, with no signs of active inflammation or infection.

Fundus autofluorescence (FAF) shows a hypoautofluorescent area without hyperautofluorescent margins—further supporting the absence of active inflammation or infection.

Optical coherence tomography (OCT) through the lesion reveals a large, excavated, coloboma-like chorioretinal defect located temporal to the fovea.
Diagnosis: Chorioretinal Scar of Congenital Toxoplasmosis
Discussion
Congenital toxoplasmosis is a serious condition caused by Toxoplasma gondii, a protozoan parasite transmitted from an infected mother to the fetus during pregnancy. While maternal infection is often asymptomatic or mild, transplacental transmission can result in significant fetal damage, especially to the central nervous system and eyes.
Transmission risk increases with gestational age; however, the severity of the infection is typically higher when it occurs early in pregnancy. Clinical manifestations may be present at birth or develop months to years later. Sabin’s tetrad summarizes the classical clinical features:
- Hydrocephalus
- Chorioretinitis
- Intracranial calcifications
- Intellectual disability
Diagnosis is primarily based on serologic testing, PCR, and neuroimaging (MRI or CT). Treatment is not indicated in inactive forms of the disease. Management is reserved for cases with active infection or reactivation, particularly when vision-threatening.
Credit: Dr. Giovanni Di Fiore,
Università degli studi della Campania “Luigi Vanvitelli”
Instagram account: @giodifiore

